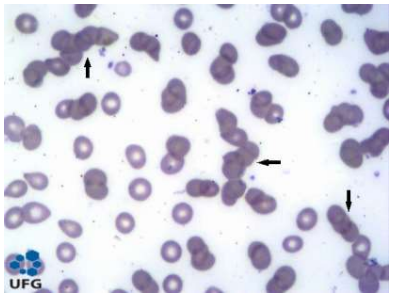
Enunciado 4632898-1

Foram encontradas 480 questões.
Os testes de coagulação são utilizados para verificar os distúrbios da hemostasia e em rotinas de pré-operatório. Para a dosagem de fibrinogênio in vitro, o plasma do paciente a ser testado, após diluído, é
misturado com
Provas
Questão presente nas seguintes provas
3788413
Ano: 2024
Disciplina: Técnicas em Laboratório
Banca: UFMT
Orgão: Pref. Campos Júlio-MT
Disciplina: Técnicas em Laboratório
Banca: UFMT
Orgão: Pref. Campos Júlio-MT
Provas:
O exame de ELISA é amplamente utilizado no laboratório para diagnóstico de doenças infecciosas, como as
doenças virais. Para o exame de ELISA direto, o que é avaliado no soro do indivíduo que está sendo
testado?
Provas
Questão presente nas seguintes provas
O teste de Coombs indireto auxilia no diagnóstico de doenças hemolíticas relacionadas à presença de
anticorpos antieritrocitários. Qual é a amostra biológica a ser analisada no teste de Coombs indireto?
Provas
Questão presente nas seguintes provas
O consumo do açaí nos estados da Amazônia Legal está associado aos casos de doença de Chagas aguda
(DCA) nessa região. Qual método de escolha é utilizado para o diagnóstico de DCA em um paciente com
menos de uma semana de sintomas?
Provas
Questão presente nas seguintes provas
A coloração de Gram classifica as bactérias em dois grandes grupos: as bactérias Gram positivas e as Gram
negativas. A classificação baseia-se na diferença das estruturas de parede celular das bactérias e como cada
uma das estruturas reage aos corantes utilizados no método de coloração. Qual corante impregnado pelas
bactérias classificadas como Gram positivas permite essa classificação?
Provas
Questão presente nas seguintes provas
De acordo com as “Boas Práticas de Gerenciamento dos Resíduos de Serviços de Saúde”, os efluentes dos
equipamentos automatizados utilizados em análises clínicas são classificados como resíduos do grupo
Provas
Questão presente nas seguintes provas
3788408
Ano: 2024
Disciplina: Técnicas em Laboratório
Banca: UFMT
Orgão: Pref. Campos Júlio-MT
Disciplina: Técnicas em Laboratório
Banca: UFMT
Orgão: Pref. Campos Júlio-MT
Provas:
Os riscos biológicos são classificados em quatro diferentes grupos de acordo com características específicas.
Qual a classificação de risco biológico para um agente patogênico que pode provocar enfermidades humanas
graves, podendo propagar-se de uma pessoa infectada para outra e para o qual existe profilaxia e/ou
tratamento?
Provas
Questão presente nas seguintes provas
Observe a imagem a seguir de um esfregaço de sangue total.
Como são chamadas as estruturas apontadas pelas setas e que indicam aumento das proteínas plasmáticas?
Provas
Questão presente nas seguintes provas
3788406
Ano: 2024
Disciplina: Técnicas em Laboratório
Banca: UFMT
Orgão: Pref. Campos Júlio-MT
Disciplina: Técnicas em Laboratório
Banca: UFMT
Orgão: Pref. Campos Júlio-MT
Provas:
A maneira mais comum de calcular os valores sanguíneos de colesterol LDL e VLDL é por meio da
Fórmula de Friedewald. Nesse método, o LDL e o VLDL são calculados a partir das taxas de colesterol
total, colesterol HDL e triglicérides. Utilizando essa fórmula, quais os valores de colesterol LDL e colesterol
VLDL, respectivamente, de um paciente que apresenta 195 mg/dL de colesterol total, 35 mg/dL de
colesterol HDL e 250 mg/dL de triglicérides?
Provas
Questão presente nas seguintes provas
3788405
Ano: 2024
Disciplina: Técnicas em Laboratório
Banca: UFMT
Orgão: Pref. Campos Júlio-MT
Disciplina: Técnicas em Laboratório
Banca: UFMT
Orgão: Pref. Campos Júlio-MT
Provas:
Um técnico, ao iniciar a sua rotina de trabalho, percebe que estão faltando no laboratório tubos de coleta de
sangue a vácuo de tampa roxa. Qual exame terá sua realização prejudicada por conta da falta desses tubos?
Provas
Questão presente nas seguintes provas
Cadernos
Caderno Container